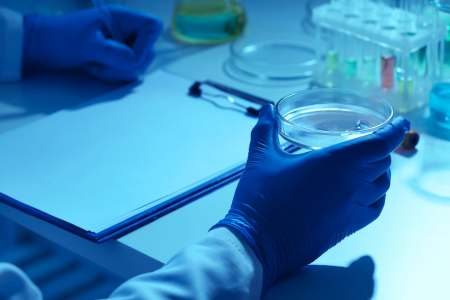

The cost of your homogenizer is a more complex formula than you may have thought.
Tissue homogenizers represent a significant investment for laboratories, with prices ranging from a few hundred dollars for basic, handheld models to $50,000+ for advanced systems.
In almost every case, the cost of your sample homogenizer correlates to the price you put on your samples and your body of work.
Of course, that abstractness can be broken down into more tangible factors.
The materials used to craft it. The precision it achieves. The control you can exert over the process. The safety built in.
Understanding the factors that influence pricing can help laboratory managers, researchers, and procurement specialists make informed purchasing decisions that balance budget constraints with research requirements.
We hope you can use the information in this report to get budget approval for the instrument that will benefit your work most, without compromising on pieces that add to your workload, your stress, and the quality of your output.
We hope this helps.
Key Pricing Factors
It’s not only about the brand on the box (although we all know that plays a role too).
But when you understand the pricing elements outside of that sticker, you can make a better decision for your application and build a more compelling case for allocating budget to this specific piece of equipment.
In the sections below, we’ve appended general dollar values to each factor (where we feel confident doing so). This is primarily for illustrative purposes. Use this as a guide and not gospel.
1. The type of homogenizer is the most obvious starting point.
Different homogenization technologies command different price points based on complexity, precision, and capabilities:
| Type | Typical price range | Price drivers |
| Blade/Knife Mills | $500-$10,000 | Motor power, blade quality, speed control precision |
| Bead Mill Homogenizers | $2,000-$25,000 | Oscillation mechanism, sample capacity, temperature control |
| Rotor-Stator Homogenizers | $1,500-$15,000 | RPM capability, probe materials, motor quality |
| Ultrasonic Homogenizers | $3,000-$20,000 | Wattage, frequency precision, programmability |
| Pressure-Based Systems | $15,000-$50,000+ | Maximum pressure capabilities, flow rates, material quality |
| Cryogenic Grinders | $8,000-$30,000 | Cooling efficiency, grinding mechanism, safety features |
| Heat-Free Technologies | $20,000-$45,000 | Proprietary technology, efficiency gains, temperature maintenance |
2. If you want to process more samples, you’re going to invest more.
Processing capacity
- Single-sample processors: Generally lower cost ($1,000-$8,000)
- Multi-sample processors: Mid-range ($8,000-$25,000)
- High-throughput systems: Premium pricing ($25,000-$50,000+)
Speed and power
- Higher RPM/oscillation speeds = Higher price
- More powerful motors = Higher price
- Wider speed ranges = Higher price

Temperature control/management
- Basic models (no temperature control): Lower cost
- Cooling capability: +$3,000-$10,000
- Precision temperature maintenance: +$5,000-$15,000

Homogenization efficiency
- Standard efficiency: Base pricing
- High efficiency (faster processing times): +10-30%
- Ultra-efficient (preserving sample integrity): +20-50%
3. Build quality that lasts longer adds to your purchase cost.
It’s worth noting that a higher initial purchase price almost always coincides with a lower lifetime cost of ownership.
Better build quality requires less maintenance, leads to fewer unexpected downtime incidents, and frees lab technicians from inefficient and frustrating troubleshooting that takes away from their more important responsibilities.

Instrument body construction
- Plastic housing: Lower cost
- Powder-coated steel: Mid-range
- Stainless steel: Premium
- Medical-grade materials: Highest premium

Probe/blade materials (handheld)
- Stainless steel: Standard pricing
- Titanium: +30-50%
- Ceramic: +40-70%
- Specialized alloys: +50-100%

Durability factors
- Expected lifetime of components
- Maintenance intervals
- Replacement part requirements
3. Build quality that lasts longer adds to your purchase cost.
It’s worth noting that a higher initial purchase price almost always coincides with a lower lifetime cost of ownership.
Better build quality requires less maintenance, leads to fewer unexpected downtime incidents, and frees lab technicians from inefficient and frustrating troubleshooting that takes away from their more important responsibilities.

Instrument body construction
- Plastic housing: Lower cost
- Powder-coated steel: Mid-range
- Stainless steel: Premium
- Medical-grade materials: Highest premium

Probe/blade materials (handheld)
- Stainless steel: Standard pricing
- Titanium: +30-50%
- Ceramic: +40-70%
- Specialized alloys: +50-100%

Durability factors
- Expected lifetime of components
- Maintenance intervals
- Replacement part requirements
4. How hands-off and user-friendly you want your system to be can impact the price.
Manufacturers offer a mix of features outlined in the table below. Some have moved entirely to full-color touchscreens. Others have committed to full automation, or data logging as standard.
Our Multi-Beads Shocker, for example, avoids the cost inflation associated with a fully color touchscreen LCD display because we do not feel this feature adds simplicity to the user experience. It’s an unnecessary cost to the lab, and adds a budgetary hurdle for lab managers to overcome.
User interface
- Basic manual controls: Lower cost
- Digital display with manual input: Mid-range
- Touchscreen interface: Higher cost
- Full-color interactive display: Premium
Programmability
- Fixed settings: Base price
- Adjustable parameters: +$1,000
- Programmable protocols: +$3,000
- Protocol library and customization: +$5,000
Automation features
- Manual operation: Base price
- Semi-automated: +$2,000-$3,000
- Fully automated: +$5,000-$8,000
- Robotic integration capability: > +$15,000
Software
- Basic operation software: Included
- Data logging: +$1,000
- Analysis software: +$2,000
- Network integration: +$2,000
- Remote monitoring capabilities: +$5,000
5. How much can one instrument do? More applications, higher cost.
Interdepartmental sharing can lower the purchase investment for individual departments, and lead to a much lower lifetime cost of ownership.
There’s a strong argument for investing in a homogenizer that’s appropriate for a greater range of applications and sharing the cost with your friends down the hall.
Tissue type versatility
- Single tissue type specialization: Lower cost
- Multi-tissue capability: Mid-range
- Universal processing capability: Premium
Volume range
- Fixed volume processing: Lower cost
- Limited range adjustment: Mid-range cost
- Wide volume range capability: Higher cost
- Micro-to-macro volume processing: Premium

Consumables
and accessories
- Proprietary vs. standard consumables
- Required accessory costs
- Consumable replacement frequency
6. Do you need to spend more for the manufacturer you know?
The brands you commonly work with may mark prices up to capitalize on familiarity and reputation.
But there are other factors, like how novel the instrument is or where it’s manufactured. Sometimes a piece of equipment can serve an unmet need and demand a higher premium for the value it provides, even if it’s from a smaller name manufacturer.
5. How much can one instrument do? More applications, higher cost.
Interdepartmental sharing can lower the purchase investment for individual departments, and lead to a much lower lifetime cost of ownership.
There’s a strong argument for investing in a homogenizer that’s appropriate for a greater range of applications and sharing the cost with your friends down the hall.
Tissue type versatility
- Single tissue type specialization: Lower cost
- Multi-tissue capability: Mid-range
- Universal processing capability: Premium
Volume range
- Fixed volume processing: Lower cost
- Limited range adjustment: Mid-range cost
- Wide volume range capability: Higher cost
- Micro-to-macro volume processing: Premium
Consumables and accessories
- Proprietary vs. standard consumables
- Required accessory costs
- Consumable replacement frequency
6. Do you need to spend more for the manufacturer you know?
The brands you commonly work with may mark prices up to capitalize on familiarity and reputation.
But there are other factors, like how novel the instrument is or where it’s manufactured. Sometimes a piece of equipment can serve an unmet need and demand a higher premium for the value it provides, even if it’s from a smaller name manufacturer.

Manufacturer reputation
- New market entrants: Generally lower pricing
- Established manufacturers: Stable pricing
- Premium brands: 30-50% price premium

Manufacturer reputation
- New market entrants: Generally lower pricing
- Established manufacturers: Stable pricing
- Premium brands: 30-50% price premium

Research & development investment
- Basic technology adoption: Lower cost
- Moderate R&D investment, novel use case: Mid-range
- Cutting-edge innovation: Premium pricing

Research & development investment
- Basic technology adoption: Lower cost
- Moderate R&D investment, novel use case: Mid-range
- Cutting-edge innovation: Premium pricing

Manufacturing location
- Emerging market manufacturing: Lower cost
- Developed nation manufacturing: Higher cost
- Country-specific manufacturing standards impact cost-quality

Manufacturing location
- Emerging market manufacturing: Lower cost
- Developed nation manufacturing: Higher cost
- Country-specific manufacturing standards impact cost-quality
7. Is it worth getting help and support from the manufacturer?
Yes. Especially if this is a new type of equipment to you, your manager, or your technicians. The increase in cost is worth every cent.
Warranty coverage
- Basic warranty (1 year): Standard
- Extended warranty options: +5-15% per year
- Comprehensive coverage: +10-25% per year
Service agreements
- Pay-per-service model: Lower initial cost
- Basic service agreement: +8-15% of purchase price
- Premium service package: +15-25% of purchase price
- 24/7 emergency support: +20-30% of purchase price
Training and education
- Basic operator manual: Included
- Online training resources: +$500-$1,000
- On-site training: +$2,000-$8,000
- Advanced application training: > +$5,000
7. Is it worth getting help and support from the manufacturer?
Yes. Especially if this is a new type of equipment to you, your manager, or your technicians. The increase in cost is worth every cent.
Warranty coverage
- Basic warranty (1 year): Standard
- Extended warranty options: +5-15% per year
- Comprehensive coverage: +10-25% per year
Service agreements
- Pay-per-service model: Lower initial cost
- Basic service agreement: +8-15% of purchase price
- Premium service package: +15-25% of purchase price
- 24/7 emergency support: +20-30% of purchase price
Training and education
- Basic operator manual: Included
- Online training resources: +$500-$1,000
- On-site training: +$2,000-$8,000
- Advanced application training: > +$5,000
8. Market-specific factors play a role in your cost as well
Geography - not just for grade 7 anymore
The region where you're purchasing can dramatically impact pricing. Sometimes by 30% or more for identical equipment. In North America, list prices tend to be transparent but firm. European markets often have higher base prices that include more comprehensive service packages. Asia-Pacific regions may offer lower initial pricing but with potential hidden costs for service and support.
Import duties alone can add anywhere from 5-25% to the purchase price. Many labs are surprised when the final landed cost includes not just the duties, but additional customs processing fees, VAT or sales tax, and sometimes even "technology transfer" fees.
Regional regulatory requirements also create price disparities. For example, equipment destined for clinical use in Europe requires CE-IVD marking, which typically adds 15-20% to the base price compared to the research-use-only version of the same instrument.
8. Market-specific factors play a role in your cost as well
Geography - not just for grade 7 anymore
The region where you're purchasing can dramatically impact pricing. Sometimes by 30% or more for identical equipment. In North America, list prices tend to be transparent but firm. European markets often have higher base prices that include more comprehensive service packages. Asia-Pacific regions may offer lower initial pricing but with potential hidden costs for service and support.
Import duties alone can add anywhere from 5-25% to the purchase price. Many labs are surprised when the final landed cost includes not just the duties, but additional customs processing fees, VAT or sales tax, and sometimes even "technology transfer" fees.
Regional regulatory requirements also create price disparities. For example, equipment destined for clinical use in Europe requires CE-IVD marking, which typically adds 15-20% to the base price compared to the research-use-only version of the same instrument.


Your industry might be targeted to pay more
The exact same homogenizer model from some manufacturers can have dramatically different price points based solely on who's buying it.
We believe in fair, equitable pricing. And do not subscribe to any of the pricing philosophies below. But it’s worth noting, since you’re the one buying.
- Academic institutions typically receive the most favorable pricing. Why? Some manufacturers view these relationships as pathways to future publications, students becoming customers, and industry partnerships.
- Government and research institutes sometimes see moderate discounts (10%, maybe) but with stricter procurement requirements that sometimes negate these savings through administrative overhead.
- Commercial/industrial laboratories typically pay near list price from any manufacturer, with discounts primarily based on volume rather than sector. The instruments are enabling the business to profit, and it’s seen as an investment.
- Pharmaceutical and clinical diagnostic sectors often face higher pricing due to the extensive documentation, validation, and compliance requirements.
Your industry might be targeted to pay more
The exact same homogenizer model from some manufacturers can have dramatically different price points based solely on who's buying it.
We believe in fair, equitable pricing. And do not subscribe to any of the pricing philosophies below. But it’s worth noting, since you’re the one buying.
- Academic institutions typically receive the most favorable pricing. Why? Some manufacturers view these relationships as pathways to future publications, students becoming customers, and industry partnerships.
- Government and research institutes sometimes see moderate discounts (10%, maybe) but with stricter procurement requirements that sometimes negate these savings through administrative overhead.
- Commercial/industrial laboratories typically pay near list price from any manufacturer, with discounts primarily based on volume rather than sector. The instruments are enabling the business to profit, and it’s seen as an investment.
- Pharmaceutical and clinical diagnostic sectors often face higher pricing due to the extensive documentation, validation, and compliance requirements.


The pricing landscape is competitive, sometimes
Market dynamics profoundly impact pricing strategies. In saturated segments like basic rotor-stator homogenizers, where 8-10 major manufacturers compete, price competition is fierce, with frequent promotional discounting to gain market share.
Conversely, specialized technologies with limited competition don’t share this pricing flexibility. When a small number of manufacturers offer a similar solution, price elasticity decreases significantly. Shopping around when you find a unique solution becomes a poor use of time.
Technological differentiation also creates pricing power. A homogenizer that delivers demonstrably better downstream results will require a higher initial investment over functionally similar but less effective alternatives, especially when the manufacturer can demonstrate that the higher initial investment produces overall cost savings through reduced sample requirements and improved experimental outcomes.


9. Pricing opportunities that could work in your favor
Whether you’re in a rush or not, there are factors you can use to your advantage.

Quantity discounts
- Single unit purchase: List price
- Small volume (2-5 units): 3-5% discount
- Medium volume (6-20 units): 5-10% discount
- Large volume (20+ units): 10-15% discount

Bundling opportunities
- Instrument only: Base price
- Instrument + consumables: 1-3% discount
- Instrument + accessories: 3-10% discount
- Complete laboratory solution: 10-15% discount

Negotiation leverage
- End of fiscal year timing
- Competitive bids
- Long-term supply agreements
- Research partnerships
There are hidden costs you might not think about often, but can and should factor into purchases like this (if you need more than a handheld homogenizer)
Beyond the initial purchase price, several factors can significantly impact the total cost of ownership.
Operational costs
- Power consumption. High-power units increase utility costs
- Cooling requirements. Liquid nitrogen or refrigeration costs
- Consumable usage. Beads, tubes, probes, etc.
-
Sample preparation materials. Buffers, reagents, etc.


Maintenance expenses
- Most homogenizers require quarterly to annual maintenance, costing 5-15% of the purchase price annually. Heat-generating models typically require more frequent service due to mechanical stress.
- Critical components like rotor-stator assemblies ($800-$3,000), ultrasonic probes ($1,500-$4,000), or specialized beads ($200-$500 per package) need regular replacement. Lower-priced units often have higher replacement part costs and shorter intervals between replacements.
- Annual calibration services typically cost $1,000-$2,500, with GMP environments requiring more frequent and documented calibrations at premium rates.
-
Beyond the direct service costs, laboratories must account for productivity losses during equipment downtime. A single day of instrument unavailability can delay dozens of samples, potentially compromising time-sensitive experiments and costing thousands in researcher time and materials.


Infrastructure requirements
- Lab space. Beyond the footprint of the instrument itself (ranging from benchtop to dedicated workstation), facilities must consider clearance requirements, operator workspace, and sometimes dedicated rooms for noisy operations. This space carries a real estate cost of $300-$1,000 per square foot in modern research facilities.
- Ventilation. High-power homogenizers, especially ultrasonic models, may require specialized ventilation to manage aerosols and heat. Ventilation system modifications typically cost $5,000-$25,000 depending on existing infrastructure.
- Electrical supply. High-power units may require dedicated circuits, voltage stabilization, or even three-phase power. Electrical infrastructure upgrades can cost $2,000-$15,000 depending on existing capacity.
- Safety. Personal protective equipment, splash guards, hearing protection, and safety training programs represent ongoing costs often overlooked in initial budgeting. OSHA compliance for high-energy homogenization processes can add $1,000-$3,000 annually in consumable safety equipment.


The people
- Operator training time. Initial training may require hours from each staff member depending on instrument complexity, representing hundreds to thousands of dollars in labor costs. This training must be refreshed and repeated as staff turnover occurs.
- Skills. More complex homogenizers may require dedicated technicians or higher-skilled operators commanding salaries 15-30% above entry-level laboratory staff. This can translate to an additional $10,000-$25,000 in annual personnel costs.
- Protocol development time. Before routine use, laboratories typically spend 40+ hours developing and validating homogenization protocols for their specific samples, representing $2,000-$10,000 in highly skilled labor costs that must be amortized across the instrument's lifetime.
- Data analysis. Complex homogenization processes may require verification testing and quality control analysis, adding time for skilled labor per batch of samples processed - a hidden labor cost that can exceed $10,000 annually in high-throughput environments.


The all-important cost-benefit equation
Everything has a price. For an instrument like a homogenizer - especially when working with high-value or irreplaceable samples at a large scale - it’s up to the lab’s leader to determine where the greatest value lies.
A higher initial investment may lead to…
Yield improvement
Increasing the yield from samples is a high-value proposition in many labs. A higher purchase price instrument that improves yield pays for itself more quickly and offsets many other costs (invisible costs above and others).
- When working with irreplaceable clinical samples or rare specimens, higher yields mean researchers can perform 3-5X more analyses from the same starting material. For cancer biopsies or endangered species samples, this can be the difference between conclusive results and inconclusive data.
- Projects that would require months of sample collection can proceed in weeks, potentially advancing breakthrough discoveries by months or years. For medical research, this acceleration can translate to treatments reaching patients years earlier.
- Laboratories demonstrating superior sample efficiency often secure additional funding based on their ability to maximize results from minimal samples - a key evaluation criterion for major funding bodies.
- When extraction efficiency increases (up to 5X with our Multi-Beads Shocker), reagent usage for downstream applications can decrease by 60-80%, freeing significant budget for other research priorities like additional personnel or further technology investments.


Better use of time
- Faster homogenization dramatically increases laboratory throughput. When a lab can process 40 samples daily instead of 15, project timelines compress by 60-70%. For clinical labs, this means patients receive results in hours rather than days. For research facilities, publications that might take 18 months can be completed in 7-9 months, enhancing career advancement opportunities and institutional prestige.
- Reduced hands-on time creates cascading benefits throughout the organization. Skilled scientists freed from routine homogenization tasks can focus on experimental design and data interpretation. Their highest-value activities. A laboratory investing $30,000 in automated homogenization typically recovers this cost within 8-14 months through labor reallocation alone. Furthermore, staff satisfaction and retention improve when repetitive tasks are minimized, reducing the $50,000-$100,000 cost of replacing and training specialized personnel.
- Fewer failed runs transform laboratory economics and morale. When homogenization failure rates drop from 15% to 2%, laboratories not only save thousands of dollars annually in wasted reagents and materials, but they also eliminate the emotional toll of repeated failures on team motivation. Research supervisors report spending 70-80% less time troubleshooting and rescheduling failed experiments using something like the Multi-Beads Shocker, allowing more focus on mentorship and research strategy.


Better quality output
- Consistent results fundamentally change how science progresses. When experimental variability decreases by 60-80% through improved homogenization, researchers can detect subtle but significant effects that would otherwise be lost in technical noise. For pharmaceutical development, this reproducibility can save millions by identifying non-viable candidates earlier and advancing promising compounds with greater confidence.
- Better preservation of biological molecules impacts everything downstream. When proteins retain 95% activity rather than 60%, enzyme assays become more sensitive and accurate. RNA transcriptome analysis captures low-abundance transcripts that would be degraded with inferior homogenization, potentially revealing critical biomarkers or regulatory factors. For personalized medicine applications, this integrity difference can mean identifying an effective treatment versus missing a crucial genetic indicator. A life-changing distinction for patients.
- Cleaner results build researcher confidence and reputation. When cross-contamination rates fall below detectable limits, publications face fewer challenges during peer review, and clinical laboratories avoid costly retesting and potential regulatory penalties. For forensic applications, contamination-free processing can be the difference between justice served and cases dismissed.

A futureproof lab
- When laboratory priorities shift as they inevitably do, adaptable homogenizers prevent costly equipment replacement cycles. A research group that pivots from plant genetics to microbial studies can maintain momentum without the 3-6 month procurement delay for new equipment. Core facilities serving multiple research groups report 30-40% higher utilization rates for versatile instruments, improving return on investment and institutional resource allocation.
- As scientific frontiers advance, sample types evolve. Laboratories equipped to handle emerging sample types (organoids, biofilms, novel biomaterials) secure high-profile collaborations and attract top talent
- "We can process that" versus "We'll need new equipment first" can be the difference in securing time-sensitive opportunities.


What can you expect to spend based broadly on your application?
| Application | Typical price range | Key price determinants |
| Basic research | $1,000-$8,000 | Sample throughput, tissue types |
| Genomics/transcriptomics | $10,000-$40,000 | Nucleic acid preservation, temperature control |
| Proteomics | $15,000-$45,000 | Protein integrity, customization options |
| Clinical diagnostics | $20,000-$40,000+ | Reproducibility, validation, compliance |
| Pharmaceutical development | $20,000-$40,000+ | GMP compliance, automation, documentation |
| Industrial QC | $10,000-$35,000 | Durability, throughput, standardization |
| Food science | $5,000-$30,000 | Volume capacity, cleaning features |
| Environmental analysis | $8,000-$25,000 | Sample variability handling, ruggedness |
When it’s time to spend your budget, how can you work with your budget constraints to get what you want?
If you aren’t in a hurry, pay attention to your timing.

End of fiscal quarter/year
May access discretionary budgets

Conference seasons
Special promotional pricing

New model introductions
Discounts on previous models
Financing might work to your advantage.

Outright purchase
vs. leasing

Capital equipment budgeting

Grant funding alignment

Shared resource planning
Try something creative (not always available - and not always practical)


- Equipment sharing consortia.
- Service-based models (pay-per-sample - outsourcing samples)
- Refurbished equipment market
- Demo unit acquisition
- Equipment sharing consortia.
- Service-based models (pay-per-sample - outsourcing samples)
- Refurbished equipment market
- Demo unit acquisition
Use that info to justify and validate the cost - but don’t forget that your application needs results and you’re on the hook for that
Tissue homogenizer pricing reflects a complex interplay of technological capabilities, performance specifications, quality factors, and market positioning.
That initial purchase price is important because it’s the number that gets signed off on, but we strongly feel the total cost of ownership and return on investment should guide purchasing decisions.
The Yamato Scientific Multi-Beads Shocker preserves more nucleic acid from your sample, and prevents dozens of snowballing factors from eating into your budget.
If you need something more than a handheld homogenizer, get a demo from us first and decide if your samples are precious enough and valuable enough to invest in.